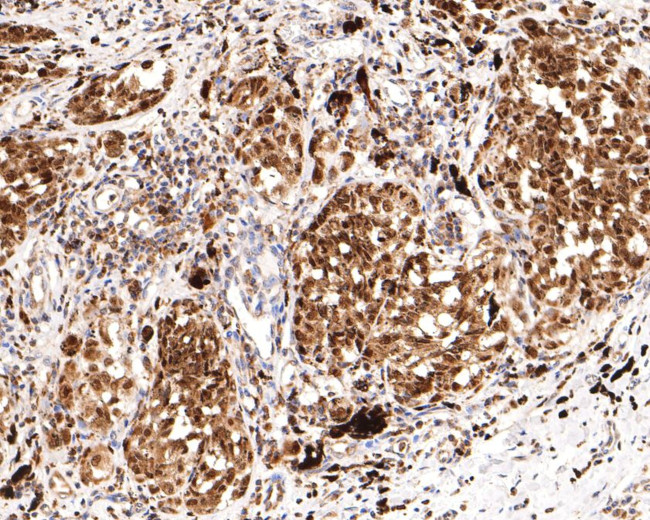
SOX10 Antibody in Immunohistochemistry (Paraffin) (IHC (P))

Search
Huabio
SOX10 Polyclonal Antibody
{{$productOrderCtrl.translations['antibody.pdp.commerceCard.promotion.promotions']}}
{{$productOrderCtrl.translations['antibody.pdp.commerceCard.promotion.viewpromo']}}
{{$productOrderCtrl.translations['antibody.pdp.commerceCard.promotion.promocode']}}: {{promo.promoCode}} {{promo.promoTitle}} {{promo.promoDescription}}. {{$productOrderCtrl.translations['antibody.pdp.commerceCard.promotion.learnmore']}}
图: 1 / 2
SOX10 Antibody (HA500503) in IHC (P)


产品信息
HA500503
种属反应
宿主/亚型
分类
类型
抗原
偶联物
形式
浓度
规格
纯化类型
保存液
内含物
保存条件
运输条件
靶标信息
SOX10 is a member of the SOX (SRY-related HMG-box) family of transcription factors involved in the regulation of embryonic development and in the determination of the cell fate. This protein may act as a transcriptional activator after forming a protein complex with other proteins. It acts as a nucleocytoplasmic shuttle protein and is important for neural crest and peripheral nervous system development. Mutations in this gene are associated with Waardenburg-Shah and Waardenburg-Hirschsprung disease.
仅用于科研。不用于诊断过程。未经明确授权不得转售。
篇参考文献 (0)
生物信息学
蛋白别名: dominant megacolon; dominant megacolon, mouse, human homolog of; MGC15649; Protein SOX-21; SOX10; SRY; SRY (sex determining region Y)-box 10; SRY-box 10; SRY-box containing gene 10; SRY-related HMG-box gene 10; Transcription factor SOX-10; Transcription factor SOX-M; unnamed protein product
基因别名: DOM; PCWH; SOX-10; SOX10; Sox21; WS2E; WS4; WS4C
UniProt ID: (Human) P56693, (Mouse) Q04888
Entrez Gene ID: (Human) 6663, (Mouse) 20665